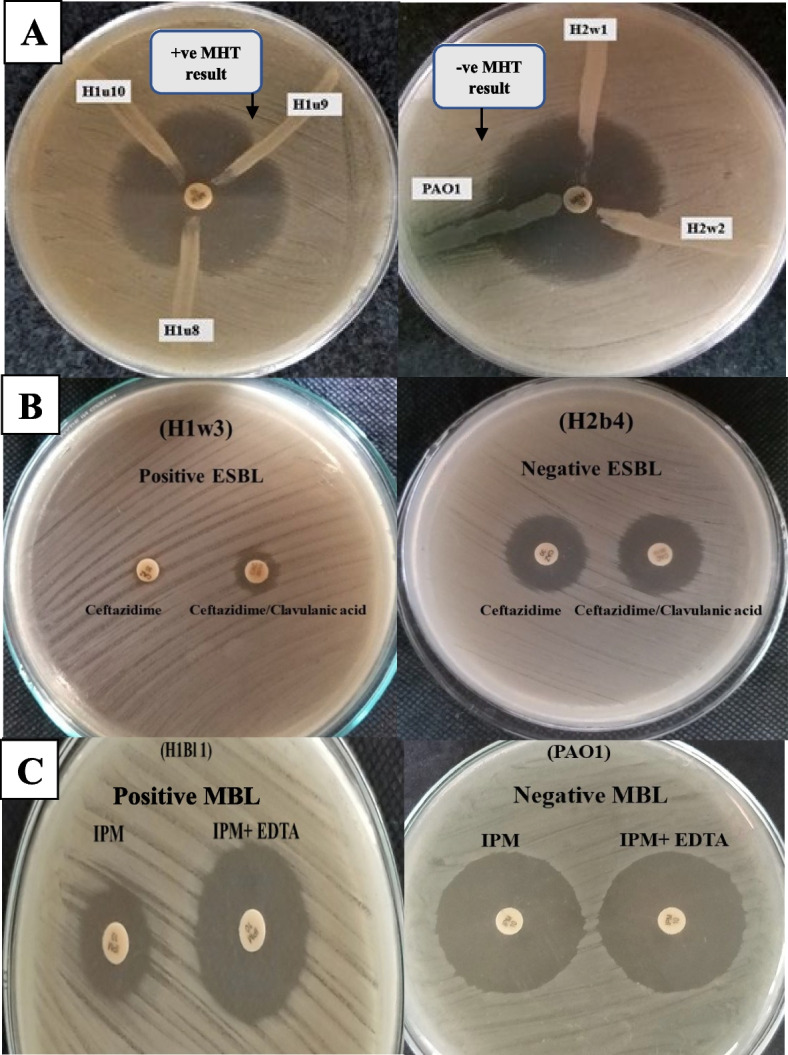
Fig. 4

Abstract
Background
The incidence of hospital-acquired infections in extensively drug-resistant Pseudomonas aeruginosa (XDR-PA) has been increasing worldwide and is frequently associated with an increase in mortality and morbidity rates. The aim of this study was to characterize clinical XDR-PA isolates recovered during six months at three different hospitals in Egypt.
Results
Seventy hospital-acquired clinical isolates of P. aeruginosa were classified into multidrug-resistant (MDR), extensively drug-resistant (XDR) and pandrug-resistant (PDR), according to their antimicrobial resistance profile. In addition, the possession of genes associated with mobile genetic elements and genes encoding antimicrobial resistance determinants among isolates were detected using polymerase chain reaction. As a result, a significant percentage of the isolates (75.7%) were XDR, while 18.5% were MDR, however only 5.7% of the isolates were non-MDR. The phenotypic detection of carbapenemases, extended-spectrum β-lactamases (ESBLs) and metallo β-lactamase (MBL) enzymes showed that 73.6% of XDR-PA isolates were carbapenemases producers, whereas 75.5% and 88.7% of XDR-PA isolates produced ESBLs and MBL respectively. In addition, PCR screening showed that oxa gene was the most frequently detected gene of carbapenemases (91.4%), while aac(6ʹ)-lb gene was mostly detected (84.3%) among the screened aminoglycosides-resistance genes. Furthermore, the molecular detection of the colistin resistance gene showed that 12.9% of isolates harbored mcr-1 gene. Concerning mobile genetic element markers (intI, traA, tnp513, and merA), intI was the highest detected gene as it was amplified in 67 isolates (95.7%). Finally, phylogenetic and molecular typing of the isolates via ERIC-PCR analysis revealed 10 different ERIC fingerprints.
Conclusion
The present study revealed a high prevalence of XDR-PA in hospital settings which were resistant to a variety of antibiotics due to several mechanisms. In addition, 98% of the XDR-PA clinical isolates contained at least one gene associated with movable genetic elements, which could have aided the evolution of these XDR-PA strains. To reduce spread of drug resistance, judicious use of antimicrobial agents and strict infection control measures are therefore essential.
Supplementary Information
The online version contains supplementary material available at 10.1186/s12866-024-03321-5.
Keywords: Pseudomonas aeruginosa, Hospital-acquired infections, Extensively drug-resistant, ERIC-PCR
Introduction
Pseudomonas aeruginosa is an opportunistic worldwide pathogen responsible for a wide range of bacterial complications, including pneumonia, endocarditis, urinary tract infections, burn and wound infections, in addition to, sepsis and bacteremia [1, 2]. This superbug has been reported to be one of the most prevalent microbes isolated from hospitalized patients, accounting for 10% of all nosocomial infections and ranking in the top three most often reported hospital-acquired pathogens [3].
P. aeruginosa is armed with a diverse arsenal of antimicrobial resistance mechanisms, where it can rapidly develop resistance to different antimicrobial agents by acquiring of resistance genes in movable genetic elements [1]. According to the International Nosocomial Infection Control Consortium (INICC) surveillance study, by analyzing the antimicrobial sensitivity pattern of strains obtained from patients admitted to intensive care units conducted in 45 countries, approximately 50% of P. aeruginosa infections were resistant to recently discovered and potent antibiotics [4]. Therefore, the rise of multidrug-resistant (MDR), extensively drug-resistant (XDR), and pandrug-resistant (PDR) P.aeruginosa becomes an emerging public health threat [5]. Since the use of antibiotics as the first line of treatment for bacterial infections, the emergence of XDR bacteria has raised concerns about a post-antibiotic age, in which many bacterial infections may be untreatable with conventional antibiotics [6].
Extensively drug-resistant Pseudomonas aeruginosa (XDR-PA) is defined as insusceptibility of the isolate to at least one antibiotic in all, but two or more antimicrobial categories [7–9]. Based on emerging studies, antibiotic resistance of XDR-PA is usually associated with the production of different β-lactamases, colistin resistance enzymes, aminoglycoside-modifying enzymes (AMEs), expression of outer membrane protein, and active efflux system. Furthermore, integron-carrying drug-resistant genes and bacterial biofilm production are frequently linked to elevated antibiotic resistance in XDR-PA strains [1, 10].
The incidence of hospital-acquired infections in XDR-PA has been increasing in Egypt and worldwide [11, 12]. However, there is a lack of sufficient recent studies addressing this issue in our country. Therefore, the present work aimed to characterize and determine the prevalence of XDR-PA clinical isolates associated with nosocomial infections in our country. Additionally, we aimed to investigate the various mechanisms involved in their antimicrobial resistance. The ultimate goal of this study is to develop urgent and efficient extensively drug-resistant overcoming strategies in hospitals and to prevent the emergence of pandrug-resistant P. aeruginosa strains in our region.
Methodology
Bacterial isolates
An initial collection of 125 clinical specimens were obtained from inpatients at different hospitals in Egypt in the time between September 2019 and March 2020. The protocol used in this study adheres to the ethical guidelines and the principles of handling human subjects in medical research adopted by ‘The Research Ethics Committee of the Faculty of Pharmacy at Mansoura University, Egypt, which is in accordance with the Code of Ethics of the World Medical Association (Declaration of Helsinki regarding the involvement of human subjects). The study’s protocol was approved by the committee with the ethical codes 2019–110 and 2023–16. Specimens were obtained from various clinical sources (burns, wounds, urine, sputum, blood, and pus) at three different hospitals; hospital 1 (H1), hospital 2 (H2), and hospital 3 (H3). The three hospitals selected in our study, represents large central hospitals, located in different areas in Cairo and Mansoura. These hospitals offer a wide range of medical specialties and serve patients from all over the country, which allowed us to have diverse samples and avoid limitations associated with studying only one hospital or city. Only one isolate per patient was used in the study to avoid over representation of certain strains. Seventy isolates were identified as Pseudomonas aeruginosa by streaking on cetrimide agar plates, which were then incubated for 24 h at 37◦C. The resulting colonies were examined microscopically after Gram staining and identified biochemically as being positive oxidase and catalase producers, citrate utilizers and nitrate reducers. Additionally, they exhibited a characteristic sweetish odor and produced a blue-green pigment (pyocyanin) on the cetrimide agar plates. P. aeruginosa isolates were further confirmed by molecular identification of the oprL gene specific for P. aeruginosa using the primer pair listed in Table 1. In case of H1 hospital, a total of 52 isolates (74.3% of total isolates) were identified, including 13 burn isolates (b), 14 wound isolates (w), 16 urine isolates (u), 6 sputum isolates (s), 2 blood isolates (bl), and one isolate taken from pus (p). In case of H2, a total of 15 (21.4%) isolates were identified including 11 isolates, obtained from burns (b), 3 isolates obtained from wounds (w) and one isolate taken from pus) p). In case of H3 hospital, a total of 3 (4.3%) isolates were identified from burn specimens (b). For easier identification, all isolates were coded based on the hospitals they were obtained from (H1, H2, and H3), in addition to the clinical sources: burn (b), wound (w), urine (u), sputum (s), blood (bl), and pus (p). Finally, seventy isolates were cultivated in Luria–Bertani (LB) medium at 37◦C and preserved in 25% (v/v) glycerol at—80◦C until further analysis.
Table 1.
Primers sequencesused for screening the tested genes
| Type of Gene | Target gene | Primer type | Nucleotide sequence (5′-3′) | Annealing temperature (°C) | Amplicon size (bp) | References |
|---|---|---|---|---|---|---|
| Identification gene | oprL | oprL -F | CGAGTACAACATGGCTCTGG | 53 | 116 | [13] |
| oprL -R | ACCGGACGCTCTTTACCATA | |||||
| Carbapenemase- encoding genes | ndm-1 | ndm-1-F | ACTTCCTATCTCGACATGC | 52 | 133 | [14] |
| ndm-1-R | TGATCCAGTTGAGGATCTG | |||||
| vim-1 | vim-1-F | TGTTATGGAGCAGCAACGATG | 56 | 920 | [14] | |
| vim-1-R | AAAGTCCCGCTCCAACGATT | |||||
| vim-2 | vim-2-F | GTCTATTTGACCGCGTCTATC | 55 | 774 | [15] | |
| vim-2-R | CTACTCAACGACTGAGCGAT | |||||
| oxa | oxa-F | AAGTGTGCAACGCAAATGGC | 55 | 137 | [15] | |
| oxa-R | CTGTTCCAGATCTCCATTCC | |||||
| Aminoglycosidesresistance genes | aac(6ʹ)-lb | aac(6ʹ)-lb-F | TTGCGATGCTCTATGAGTGG | 55 | 481 | [16] |
| aac(6ʹ)-lb-R | CTCGAATGCCTGGCGTGTTT | |||||
| aac(3)-II | aac(3)-II-F | GCGGAAGGCAATAACGGAG | 54 | 567 | This study, [17] | |
| aac(3)-II-R | CCAAGCATCGGCATCTCATA | |||||
| rmtB | rmtB-F | GCTTTCTGCGGGCGATGTAA | 53 | 173 | [18] | |
| rmtB-R | ATGCAATGCCGCGCTCGTAT | |||||
| aph(3')-I | aph(3ˋ)I-F | TTATGCCTCTTCCGACCATC | 53 | 222 | [17] | |
| aph(3ˋ)I-R | GCCTGAGCGAGACGAAATAC | |||||
| Colistin resistance gene | mcr-1 | mcr-1-F | AGTCCGTTTGTTCTTGTGGC | 58 | 320 | [19] |
| mcr-1-R | AGATCCTTGGTCTCGGCTTG | |||||
| Genetic marker of integron | intI | intI- F | CCGAGGATGCGAACCACTTC | 53 | 373 | [20] |
| intI- R | CCGCCACTGCGCCGTTACCA | |||||
| Genetic markers of transposon | merA | merA-F | GACCAGCCGCAGTTCGTCTA | 62 | 462 | [20] |
| merA-R | GCAGCASGAAAGCTGCTTCA | |||||
| tnp513 | tnp513-F | ATGTCGCTGGCAAGGAACGC | 64 | 200 | [1] | |
| tnp513-R | GGGTTCGCTGCGAGGATTGT | |||||
| Genetic marker of plasmid | traA | traA-F | AAGTGTTCAGGGTGCTTCTGCGC | 43 | 310 | [1] |
| traA-R | GTCATGTACATGATGACCATTT | |||||
|
Typing gene ERIC-PCR |
ERIC1 | ATGTAAGCTCCTGGGGATTCAC | 48 | variable | [21] | |
| ERIC2 | AAGTAAGTGACTGGGGTGAGCG |
F Forward, R Reverse, bp Base pair
Antimicrobial susceptibility testing for isolates
Kirby-Bauer disk diffusion method was used to identify the susceptibility of all 70 isolates to different antimicrobials using Mueller–Hinton agar plates [22]. The susceptibility pattern was determined for 16 different antimicrobials, of eight different classes including antipseudomonal carbapenems, antipseudomonal cephalosporins, aminoglycosides, antipseudomonal penicillin with β-lactamase inhibitor, monobactams, antipseudomonal fluoroquinolones, phosphonic acids, and polymyxins. In this study, the following antibiotic disks (Bioanalyse®, Turkey) were used: Gentamicin (10 μg), Tobramycin (10 μg), Amikacin (30 μg), Netilmicin (30 μg), Imipenem (10 μg), Meropenem (10 μg), Doripenem (10 μg), Ceftazidime(30 μg), Cefepime (30 μg), Ciprofloxacin (5 μg), Levofloxacin (5 μg), Piperacillin-tazobactam (100/10 μg), Aztreonam (30 μg) and Fosfomycin (200 μg). However, the susceptibilities of different isolates against colistin (colistin-sulfate, Sigma-Aldrich, Germany) and polymyxin B (Titan Media, India) were determined by broth micro-dilution method, as recommended by Clinical and Laboratory Standard Institute (CLSI) guidelines. As study controls, two standard P. aeruginosa strains PAO1 and PA14 were used as reference strains for antibiotic susceptibility testing. Bacterial isolates were classified as resistant, intermediate, or susceptible, according to the guidelines indicated by both CLSI 2020 [23] and European Committee on Antimicrobial Susceptibility Testing (EUCAST, 2021) [24]. Bacterial isolates were further classified into MDR, XDR, and PDR, according to the International standard definitions for acquired resistance. These definitions were established through a joint initiative by the European Centre for Disease Prevention and Control (ECDC) and the Centers for Disease Control and Prevention (CDC) [7–9]. Multiple antibiotic resistance (MAR) index was calculated for each isolate as the ratio between the number of antimicrobial agents to which the isolate showed resistance and the total number of antimicrobial agents to which the isolate had been assessed for susceptibility [25]. A MAR index > 0.2 indicates a ‘high-risk’ source of contamination, where antimicrobials are overused. For more information concerning strains relatedness, the unweighted pair group method with arithmetic mean clustering method (UPGMA) software was used to construct antibiotic resistance profiles dendrogram [26].
Phenotypic detection of carbapenemases, extended-spectrum β-lactamase (ESBL) and metallo β-lactamase (MBL) enzymes production
The modified Hodge test (MHT) for screening of carbapenemase production was applied to 53 XDR-PA isolates, as previously described before [15, 27–29] using meropenem disk (10 μg), in presence of an indicator strain. In this study, PAO1 was used as a negative control, while H1u16 clinical isolate (harboring all tested resistant genes) was used as a positive control. For results interpretation, a positive MHT was indicated by the presence of a clover-leaf-shaped or a distorted inhibition zone [30]. For ESBL detection, the combined disc diffusion test was performed. The tested strains were inoculated on Mueller Hinton agar plates and screened by disks of ceftazidime (CAZ-30 μg) and ceftazidime, in combination with clavulanic acid (30 μg/10 μg). For interpretation of the results, ≥ 5 mm difference between the zone of inhibition of the disk containing clavulanate, compared to the effect of antibiotic disk alone was considered as an ESBL-positive isolate [31, 32]. The test was performed for all XDR-PA isolates, in addition to negative and positive control strains. In case of MBL detection, combined disc test (CDT) was performed on the test organism inoculated onto the surface of Mueller Hinton agar plate by using two Imipenem (IMP-10 μg) disks. In detection with EDTA, ten microliters of 0.5 M EDTA solution (pH 8) were applied to one of the IMP discs. All XDR-PA isolates and control strains were subjected to the assay. The inhibitory zones of the IMP discs with and without EDTA were compared following an overnight incubation at 37 °C. As previously indicated, values more than 7 mm increase in the inhibition zone diameter for the imipenem disc in the presence of EDTA was considered as a positive test result [33].
Molecular detection of P. aeruginosa resistance genes and genes associated with mobile genetic elements
The possession of antimicrobial resistance genes by P.aeruginosa isolates was investigated by PCR using the oligonucleotide primers listed in Table 1. PCR screening targeted the detection of carbapenem resistance genes (ndm-1, vim-1, vim-2 and oxa), four aminoglycosides resistance genes (aac (3)-II, aac(6ʹ)-lb,aph(3')-I, and rmtB) and the colistin resistance gene mcr-1. For each isolate, any DNA template for PCR was prepared by heating three to six pure colonies suspended in 100 μl of nuclease free water at 95˚C for 10 min, followed by 10 min centrifugation at 10000 xg to remove cellular debris. Using the following mixture, the PCR reaction was adjusted to a total volume of 25 μl:12.5 μl of ready-to-use Dream Taq™ Green PCR Master Mix [2x] (Thermo Scientific, US), 2 μl of target DNA,1 μl of forward primer (10 μM), 1 μl of reverse primer (10 μM), and 8.5 μl of nuclease-free water. Additionally, a negative control without a DNA template was also used. Thermo-cycling settings involved an initial denaturation step at 94 °C for 5 min, followed by 35 cycles each containing three steps: denaturation at 94 °C for 30 s, annealing at temperatures specified in Table 1 for each primer pair for 30 s, extension at 72 °C for 1 min, and finally an extension step at 72˚C for 7 min. Agarose gel electrophoresis using 1.5% agarose gels was used to analyze the PCR products, followed by ethidium bromide staining to visualize the gels under UV radiation. The amplicons produced were compared with GeneRuler 100 bp plus (Thermo Fisher ScientificTm,UK) DNA marker. Similarly, PCR was also carried out to detect the possession of different mobile genetic element markers including integron (intI) gene, transposon (tnp51 and merA) genes and plasmid (traA) gene.
Molecular typing by Enterobacterial repetitive intergenic consensus PCR (ERIC-PCR)
Using oligonucleotide primers (ERIC-1 and ERIC-2), listed in Table 1, molecular genotyping of seventy P. aeruginosa isolates was performed by ERIC-PCR assay [21]. For each PCR reaction, amplification program started with an initial denaturation of DNA at 95°C for 5 min, followed by 35 cycles of denaturation at 95°C for 40 s, annealing at 48°C for 1 min, and extension at 72°C for 1.5 min. After a final elongation step at 72 °C for 7 min, the resulting patterns obtained were visualized under UV and the results interpreted using GelJ ® software [34]. A similarity matrix, based on Pearson correlation (optimization 1%; position tolerance 1%), was calculated, and the corresponding dendrogram was constructed according to their similarities using the unweighted pair group method with arithmetic averages (UPGMA) [35, 36].
Statistical analysis and data interpretation
Data was analyzed using SPSS software, version 25 (SPSS Inc., PASW statistics for windows version 25. Chicago: SPSS Inc.). Qualitative data were described using numbers and percentages. The significance of the results was judged at the (≤ 0.05) level. Chi-Squareand Monte Carlo tests were used to compare qualitative data between groups (XDR, MDR and non-MDR) and groups (H1, H2 and H3) as appropriate.
Results
Isolation and identification of the isolates
A total of 70 isolates were identified as P. aeruginosa, where the selected isolates were all associated with hospital-acquired infections, which was not present during the time of admission but occurring during the process of receiving health care after 48 h of hospital admission. The oprL gene was amplified in all P. aeruginosa isolates confirming their identification (Table S1).
Antimicrobial susceptibility testing and resistance pattern of the isolated P. aeruginosa
The antimicrobial susceptibility testing for the seventy isolates showed a high frequency of resistance against gentamicin (94.29%), ciprofloxacin (92.86%) and levofloxacin (92.86%). In contrast, the lowest frequencies of resistance were observed toward aztreonam (24.29%). However, intermediate levels of resistance were detected for fosfomycin (32.86%) and meropenem (55.71%). Moreover, it was found that 92.86% and 95.71% of the isolates were resistant to colistin-sulfate and polymyxin B respectively (Fig. 1).
Fig. 1.
Resistance percentage of P. aeruginosa isolates to different antimicrobials. CN:gentamicin, TOB: tobramycin, AK: amikacin, NET: netilmicin, IPM: imipenem, MEM: meropenem, DOR: doripenem, CAZ: ceftazidime, FEP: cefepime, CIP: ciprofloxacin, LEV: levofloxacin, TPZ: piperacillin-tazobactam, ATM: aztreonam, FO: fosfomycin, CT: colistin-sulfate, PB: polymyxin B, S: sensitive, I: intermediate, R: resistant
Out of the total isolates, 53 (75.7%), 13 (18.5%), and 4 (5.7%) were classified as XDR, MDR, and non-MDR, respectively. However, no pandrug-resistant isolates were detected (Fig. 2). The differences in the distribution of XDR, MDR, and non-MDR isolates among the different clinical sources are not statistically significant, as indicated by the P-values for the Monte Carlo and chi-square tests (all P-values > 0.05) (Table 2). As demonstrated in Table 3, there is no significant difference in the proportions of XDR, compared to MDR and non-MDR isolates in each clinical source for hospital H1. However, in H2, there is a significant difference in the proportion of XDR compared to MDR and non-MDR isolates in the burn clinical source (P = 0.036). Interestingly, concerning H3, a significant P-value 0.0001 is obtained, which indicates a remarkable difference between the proportion of non-MDR, compared to XDR and MDR in burn specimens.
Fig. 2.

Percentage of different resistance categories among total clinical isolates of P.aeruginosa XDR: Extensively-drug resistant, MDR:Multidrug-resistant, Non-MDR: Non- multidrug resistant
Table 2.
Distribution of XDR, MDR and Non-MDR samples among Pseudomonas aeruginosa clinical isolates obtained from different clinical sources
| Clinical source | Total number of isolates | XDR isolates no. (%) | MDR isolates no. (%) | Non-MDR (Sensitive) isolates no. (%) | χ2/MC | P value |
|---|---|---|---|---|---|---|
| Burn | 27 | 17 (63%) | 8 (29.6%) | 2 (7.4%) | 4.06 | 0.131 |
| Wound | 17 | 15 (88.2%) | 1 (5.9%) | 1 (5.9%) | 2.41 | 0.299 |
| Urine | 16 | 15 (93.8%) | 0 (0%) | 1 (6.3%) | 4.75 | 0.09 |
| Sputum | 6 | 3 (50%) | 3 (50%) | 0 (0%) | 4.43 | 0.109 |
| Blood | 2 | 2 (100%) | 0 (0%) | 0 (0%) | 0.66 | 0.719 |
| Pus | 2 | 1 (50%) | 1 (50%) | 0 (0%) | 1.39 | 0.498 |
| Total no. of isolates | 70 | 53 (75.7%) | 13 (18.6%) | 4 (5.7%) |
XDR Extensively-drug resistant, MDR Multidrug-resistant, Non-MDR Non- multidrug resistant, MC Monte Carlo test, χ2 Chi-Square test, P probability
Table 3.
Distribution of XDR, MDR and Non-MDR samples among P.aeruginosa clinical isolates obtained from different clinical sources and different hospitals
| Hospital | Clinical source | Number of isolates | XDR no N = 53 |
MDR no N = 13 |
Non-MDR no N = 4 |
χ2/MC | P value |
|---|---|---|---|---|---|---|---|
| H1 | burn | 13 | 10 | 3 | 0 | 1.09 | 0.579 |
| wound | 14 | 13 | 1 | 0 | 2.91 | 0.233 | |
| urine | 16 | 15 | 0 | 1 | 4.75 | 0.093 | |
| sputum | 6 | 3 | 3 | 0 | 4.44 | 0.109 | |
| blood | 2 | 2 | 0 | 0 | 0.66 | 0.719 | |
| pus | 1 | 0 | 1 | 0 | 4.45 | 0.108 | |
| H2 | Burn | 11 | 6 | 5 | 0 | 6.59 | 0.036* |
| Wound | 3 | 2 | 0 | 1 | 4.8 | 0.09 | |
| pus | 1 | 1 | 0 | 0 | 0.325 | 0.850 | |
| H3 | burn | 3 | 1 | 0 | 2 | 21.70 | 0.0001* |
| Total no. of isolates | 70 | 53 | 13 | 4 | |||
XDR Extensively-drug resistant, MDR Multidrug-resistant, Non-MDR Non- multidrug resistant, MC Monte Carlo test, χ2 Chi-Square test, P probability
(*) means significant
As illustrated in Fig. 3, the MDR isolates showed high resistances to gentamicin, ciprofloxacin, levofloxacin and polymyxin B antimicrobials, while all of the MDR isolates were sensitive to aztreonam antibiotic. The MARI ranged from 0.38 to 0.81, and the dendrogram showed that MDR isolates represent 12 unique antibiotic resistance profiles. Regarding XDR isolates, they showed high resistance to gentamicin, tobramycin, ciprofloxacin, levofloxacin and ceftazidime, while fosfomycin and aztreonam were the most effective antimicrobial agents. The MARI ranged from 0.56 to 0.94, and the 53 XDR isolates displayed 29 antibiotic resistance profiles, where P2 and P3 profiles each included 7 isolates from H1 and one isolate from H2, however P4 included 6 isolates from H1 and 2 isolates from H2.
Fig. 3.
Heat map showing antibiotic resistance profiles and MARI of MDR and XDR P.aeruginosa isolates, MARI: Multiple antibiotic resistance index, dendrogram was constructed using UPGMA software, H1: Hospital 1, H2: Hospital 2, H3: Hospital 3, b: burn, w: wound, u: urine, bl: blood, s: sputum, p: pus
Phenotypic detection of carbapenemases, extended-spectrum β-lactamase (ESBL), and Metallo β-lactamase (MBL) enzymes production
Modified Hodge test (MHT) was performed on 53 XDR-PA isolates, where thirty nine isolates (73.6% of XDR) showed a clover leaf-like indentation at the point of intersection of the isolate with the indicator strain, within the inhibition zone of the meropenem disk, confirming positive carbapenemase enzyme production. On the other hand, 14 isolates (26.4% of XDR) showed negative MHT results (Figs. 4A and 5). The presence of (ESBL) enzymes was studied on XDR-PA isolates through the combined disk diffusion test indicating 40 isolates of XDR (75.5% of XDR) and considered as ESBLs producers. In contrast,13 isolates (24.5% of XDR) showed negative results (Figs. 4B and 5). The MBL enzymes detection by the combined disk test (CDT) showed that 47 isolates (88.7% of XDR) were MBL enzyme producers, while 6 isolates (11.3% of XDR) exhibited non-enzyme producing capabilities (Figs. 4C and 5).
Fig. 4.
Phenotypic detection of β-lactamase production for P. aeruginosa clinical isolates. A Modified Hodge test for carbapenemase productiondetection. B Combined disk diffusion test for (ESBLs) productiondetection. C Combined disk test was for MBL detection. MHT: Modified-Hodge test, ESBL: Extended-spectrum β-lactamase, MBL: Metallo β-lactamase, IPM: Imepenim
Fig. 5.
ERIC-PCR Clustering dendrogram of 70 P. aeruginosa clinical isolates at 80% similarity using UPGMA, each clinical source, date of collection, resistance category, genotypic profile and β-lactamase phenotypic profile ofthe isolates are also shown, H1: Hospital 1, H2: Hospital 2, H3: Hospital 3, b: burn, w: wound, u: urine, bl: blood, s: sputum, p: pus
Molecular analysis of the strains
PCR screening showed that oxa was the most frequently detected gene among the screened carbapenemase-encoding genes, as it was amplified in 64 isolates (91.4%), followed by vim-1 and ndm-1 genes, which were amplified in 52 isolates (74.3%) and 32 isolates (45.7%) respectively. On the other hand, vim-2 gene was the least detected gene, as it was present only in 15 isolates (21.4%) (Fig. 1A Supp.). Among the screened aminoglycosides-resistance genes, aac(6ʹ)-lb was the highest detected gene as it was amplified in 59 isolates (84.3%). Concerning aac(3)-II and rmtB genes, they were amplified in 57 (81.4%) and 52 isolates (74.3%) respectively, while aph (3')-I gene was the least detected gene, as it was detected only in 22 isolates (31.4%). Intrestingly, 52 isolates (74.3%) harboured at least three aminoglycosides-resistance genes (Fig. 1B Supp.). In this study, the genetic detection of the colistin resistance (mcr-1) was positive for 9 isolates (12.9%), where 8 of them were colistin resistant (Fig. 1C Supp.). Intrestingly, intI was the most predominant gene among the screened mobile genetic element markers, as it was amplified in 67 isolates (95.7%), followed by tnp513 and merA genes, as they were detected in 47 (67.1%) and 43 ( 61.4%) isolates, respectively. In contrast, traA was the least detected gene, as it was harbored by only 23 isolates (32.9%) (Fig. 1D Supp.).
Distribution of resistance genes among different hospitals, MDR and XDR isolates
In this study, the oxa gene was the most commonly detected carbapenemase-encoding gene in H1 hospital. However, in H2 hospital, both oxa and ndm-1 genes were the most predominant. In case of H3 hospital, oxa and vim-1 genes were the most commonly detected. Interestingly, ndm-1 gene was detected in 93.3% of isolates from H2 hospital, which was significantly higher than in the other hospitals (P < 0.05, Table 4).
Table 4.
Distribution of resistance genes among different hospitals, MDR and XDR isolates
| Gene type | Gene | Number of isolates | P value | Number of isolates | P value | ||||
|---|---|---|---|---|---|---|---|---|---|
| Total no of isolates n = 70 (%) |
H1 n = 52 (%) |
H2 n = 15 (%) |
H3 n = 3 (%) |
MDR isolates n = 13 (%) | XDR isolates n = 53 (%) | ||||
| Carbapenemase- encoding genes | ndm-1 | 32 (45.7%) | 17 (32.7%) | 14 (93.3%) | 1 (33.3%) | 0.0001* | 12 (92.3%) | 18 (33.9%) | 0.001* |
| vim-1 | 52 (74.3%) | 41 (78.8%) | 8 (53.3%) | 3 (100%) | 0.079 | 8 (61.5%) | 41 (77.4%) | 0.242 | |
| vim-2 | 15 (21.4%) | 11 (21.2%) | 4 (26.7%) | 0 (0%) | 0.587 | 1 (7.7%) | 13 (24.5%) | 0.183 | |
| Oxa | 64 (91.4%) | 47 (90.4%) | 14 (93.3%) | 3 (100%) | 0.809 | 12 (92.3%) | 48 (90.6%) | 0.844 | |
| Aminoglycoside resistance genes | aac(6ʹ)-lb | 59 (84.3%) | 44 (84.6%) | 12 (80%) | 3 (100%) | 0.679 | 11 (84.6%) | 45 (84.9%) | 0.979 |
| aac(3)-II | 57 (81.4%) | 42 (80.8%) | 12 (80%) | 3 (100%) | 0.698 | 11 (84.6%) | 43 (81.1%) | 0.770 | |
| rmtB | 52 (74.3%) | 40 (76.9%) | 9 (60%) | 3 (100%) | 0.242 | 9 (69.2%) | 40 (75.5%) | 0.645 | |
| aph(3')-I | 22 (31.4%) | 17 (32.7%) | 5 (33.3%) | 0 (0%) | 0.486 | 0 (0%) | 22 (41.5%) | 0.004* | |
| Colistin resistance gene | mcr-1 | 9 (12.9%) | 8 (15.4%) | 1 (6.7%) | 0 (0%) | 0.535 | 2 (15.4%) | 7 (13.2%) | 0.165 |
(*) means significant
Among aminoglycoside resistance genes, aac(6ʹ)-lb gene was the most commonly detected in H1 hospital. However, in H2 hospital, both aac(6ʹ)-lb and aac(3)-II genes were the most prevalent. Similarly, in H3 hospital, aac(6ʹ)-lb, aac(3)-II, and rmtB genes were the most commonly detected.
Concerning mcr-1 colistin resistance gene, it was detected most frequently in H1 hospital, followed by H2 hospital (Table 4).
Statistical analysis showed that there was no significant correlation between the prevalence of resistance genes and the resistance category of the isolates, except for the aph(3')-I and ndm-1 genes, where the prevalence of aph(3')-I was higher in XDR (41.5%), compared to MDR (0%) isolates (P = 0.004), while ndm-1 was most prevalent among MDR (92.3%) than XDR (33.9%) isolates (P = 0.001, Table 4).
ERIC-PCR typing of P. aeruginosa clinical isolates
The ERIC-PCR, performed on 70 P. aeruginosa isolates showed different DNA fingerprints. The dendrogram map (Fig. 5) revealed 10 different groups, in which 4 isolates had unique ERIC types, while the remaining 66 strains were clustered into six clusters (A-F) based on 80% similarity. Clusters F and A included the largest number of ERIC patterns, 29 (41.4%) and 14 (20%), respectively. However lower percentages could be obtained in clusters B, C and D, with 7 (10%), 6 (8.6%) and 6 (8.6%) patterns, respectively. The lowest percentage was identified in group E, which included only 4 (5.7%) ERIC patterns. Interestingly, it was found that both A and B clusters grouped only XDR isolates collected from H1 hospital. However, cluster C contained only isolates from H2 hospital, while cluster E grouped the isolates from H3 hospital (with similarity > 95%), in addition to one isolate from H2 hospital. Moreover, most of the MDR isolates (84.6%) grouped into cluster F.
Distribution of the mobile genetic element genes among the isolates
Distribution of the mobile genetic element determinants (merA, intI, traA, and tnp513) among XDR-PA isolates revealed that intI was the most frequently detected gene, as it was amplified in 52 isolates (98.1% of XDR-PA), while traA was the least detected as it was amplified in 13 (24.5% of XDR-PA) isolates (Fig. 5). The current study revealed that 98% of XDR P. aeruginosa isolates harbored at least one gene associated with movable genetic elements. Among these isolates, 23 (43.4%) contained 2 genes, while 19 (35.8%) and 6 (11.3%) of isolates coharbored 3 and 4 genes, respectively. In contrast, one isolate (H1b11) was found lacking of these genes. Concerning the MDR isolates, intI was the most prevalent gene, amplified in 12 MDR isolates (92%). However, merA was the least detected, amplified in 7 MDR isolates (53.8%). In addition, all MDR P. aeruginosa isolates harbored at least one gene associated with movable genetic elements, where 5 (38.5%) MDR isolates co-harbored 3 genes, 4 (30.85%) MDR isolates co-harbored 4 genes, and 2 (15.4%) MDR isolates co-harbored 2 genes. Regarding the non-MDR isolates, merA was the most detected gene, where it was amplified in 4 (100%) isolates, while traA was the least detected as it was amplified in only 2 (50%) isolates. Moreover, 2 (50%) non-MDR isolates co-harbored 3 genes, while one (25%) isolate harbored 4 genes and another (25%) isolate harbored 2 genes (Fig. 5).
Discussion
P. aeruginosa is recognized as one of the primary causes of hospital-acquired infections (HAI), including 10 to 15% of HAI worldwide, especially in immunocompromised patients in intensive care units (ICU) [37]. XDR-PA strains represent a significant public health threat globally [1]. In the current study, 53 isolates (75.7%) were classified as extensively drug-resistant P. aeruginosa (Fig. 2). Similar findings were recently reported in Egypt, where Abd El-Baky et al., 2020, reported that 87% of P. aeruginosa isolates, obtained from different clinical sources were classified as XDR [5]. In the current study, XDR-PA isolates were obtained from three different hospitals in Egypt, located in different areas and cities, suggesting a high prevalence of XDR P. aeruginosa isolates in our region. Because of the overuse of antibiotics, XDR-PA has been unfortunately found to spread widely [38]. Susceptibility testing showed a high frequency of resistance against gentamicin (94.29%), ciprofloxacin (92.86%) and levofloxacin (92.86%). In contrast, the lowest frequencies of resistance were observed toward aztreonam (24.29%). However, intermediate levels were detected for fosfomycin (32.86%) and meropenem (55.71%). These results were concordant with a recent report from Egypt, where El-Far et al., 2021 stated that 97% of P. aeruginosa isolates were gentamicin resistant, however only 21.2% were aztreonam resistant [18]. According to Table 2, there are no significant differences in the distribution of XDR, MDR, and non-MDR isolates among different clinical sources. Similarly, Edward et al., 2023 reported also that there was no statistically significant association between the clinical source of isolates and MDR status [39]. In this study, statistical analysis showed that there was a significant difference between the proportion of XDR, compared to MDR and non-MDR in burn specimens from H2 (P = 0.036). In addition, according to the results obtained, in H3 hospital, the P-value of 0.0001 indicates a significant association between burn specimens and being non-MDR (sensitive), suggesting that burns at H3 are less likely to harbor MDR strains of bacteria. However, due to the small sample size in H3, it is important to interpret these findings with caution, therefore further studies with larger sample sizes are needed to confirm this association (Table 3).
The value of the MARI 0.200 has been applied to differentiate low- and high-risk areas, where antibiotics are abused [40]. In the current study, MAR indices ranged from 0.38 to 0.94 in most of the isolates (Fig. 3), reflecting that a high proportion of the isolates are likely to be from high-risk source and originate from an environment, where several antimicrobials are overused. Similar results were found in a previous study on P. aeruginosa, where 91.2% of the isolates had MARI higher than 0.2 [41]. As illustrated in Fig. 3, the predominance of certain resistance profiles was noticeable among the XDR clinical isolates, which may indicate a high rate of microbial dissemination of the same XDR-PA isolates between patients inter- and intra-hospital, suggesting that the incidence of hospital-acquired infections from XDR-PA has unfortunately spread widely.
One of the most efficient drugs for treating serious infections, caused by Gram-negative rods is the class of carbapenems [42]. However, there has been a recent increase in the number of pathogens displaying resistance to carbapenems. The current study revealed that 72.9% of the isolates showed resistance to at least one antipseudomonal carbapenem. Moreover, carbapenem resistance was observed in 75.8% of the overall MDR and XDR isolates (Fig. 3). Similar high resistance rates were also reported in a previous study from Egypt, where 81.8% of the MDR P. aeruginosa isolates were carbapenem resistant [18]. Our findings indicate that carbapenemases production played a crucial role in carbapenem resistance in the extensively drug-resistant P. aeruginosa isolates. Previous studies from Egypt also reported a high prevalence of carbapenemases production among carbapenem-resistant P. aeruginosa [12, 43]. However, these results were higher compared with another study conducted in China indicated that 35.1% of XDR-PA isolates were positive for MBL and MHT [1], while another study from Iran reported that only 20% of P. aeruginosa isolates were ESBLs producers [44]. Therefore, the development of carbapenemases-producing XDR-PA becomes a public health problem in our region leaving few therapeutic choices. In this study, 96.2% of XDR P. aeruginosa isolates harbored carbapenemase encoding genes, especially oxa and vim-1 (Table 4, Fig. 1A Supp.). However, Shaaban et al., 2017 previously reported that both vim-1 and vim-2 were amplified in 75% of the carbapenem resistant P. aeruginosa isolates, while ndm-1 in 50% of isolates [15]. On the other hand, different prevalence percentages were reported in a previous study from Egypt, where ndm-1 was the most frequently detected gene among the XDR-PA isolates, while vim-1 gene was only detected in 18.1% of isolates [43]. Interestingly, the coexistence of more than one carbapenemase gene is detected in 84.9% of the XDR-PA isolates in the current study (Fig. 5), as previously reported in previous studies in Egypt and worldwide [1, 15, 45, 46].
Aminoglycosides are broad-spectrum antibiotics that are highly effective against aerobic and facultative anaerobic Gram-negative bacteria. They mainly prevent protein synthesis and disrupt the cell membrane [47]. In our study, a high prevalence of aminoglycosides resistance was detected, as 94.3% of isolates showed resistance to one or more tested aminoglycosides antibiotics. In addition, all MDR and XDR isolates (100%) showed resistance to at least one aminoglycoside (Fig. 3). A similar resistance percentage was also found in a previous study conducted in Egypt, where El-Far et al., 2021 found that 97% of P. aeruginosa isolates were aminoglycoside resistant [18]. In contrast, a lower resistance percentage (43%) has been found in a previous study from Iran [48].The prevalence of resistance to aminoglycosides varies through countries for a variety of reasons, including abuse of these medications in hospitals, geographical, cultural differences and arbitrary use of the antibiotics by people without a prescription [48]. The production of aminoglycoside-modifying enzymes, in addition to16S rRNA methyltransferases are considered the primary causes of bacterial resistance to aminoglycosides. The current study showed that 95.5% of aminoglycoside-resistant isolates contained at least one AMEs gene (Fig. 5). A previous study reported that 79% of aminoglycoside-resistant P. aeruginosa isolates harbored AME-encoding genes [48], whilst El-Far et al., 2021, reported that only 59.4% of the aminoglycoside-resistant isolates possessed resistance genes [18]. Interestingly, the current study showed that 40 XDR-PA (75.5%) isolates carried at least three aminoglycosides-resistance genes. However, contrary findings were reported in another study in Saudi Arabia, where none of the P. aeruginosa isolates co-harbored more than one gene of aminoglycoside resistance [49]. The most frequently detectable aminoglycoside resistance gene was aac(6ʹ)-lb, followed by aac(3)-II and rmtB, which encodes 16S rRNA methylase, and their distribution percentages among the XDR-PA clinical isolates were 84.9%, 81%, and 75.5%, respectively (Table 4, Fig. 1B Supp.). Previous studies also reported that aac(6ʹ)-lb gene was the most prevalent in P. aeruginosa in Venezuela and Iran [37, 48]. Other previous studies reported different prevalence of AMEs genes among P. aeruginosa worldwide, where aac(6´)-II and ant(2´´)-I were the most common aminoglycoside resistance determinants found in Europe, while aph(3′)-VI, ant(2´´)-I, aac(6´)-I, mainly detected in Korea. However, aac(6´)-31/aadA1 and aadA2 were mainly found in Mexico and Brazil [50, 51]. This variation in the distribution of AMEs genes may be explained by the geographic differences, variations in prescription patterns of aminoglycosides antibiotics, or in the selection of bacterial populations [49].
Unfortunately, it has recently been noted that the number of colistin-resistant P. aeruginosa strains is increasing. Despite the increasing prevalence of such strains, no efficient commercial antibiotics have been developed yet. Therefore, it is clear that further studies on developing effective therapeutic alternatives are urgently needed [52]. Osei Sekyere, 2019 has reported that the appearance of carbapenem- and colistin-resistant determinants in a single strain marks the beginning of a new era of pandrug resistance [53]. Unfortunately, our study detected a high level of resistance toward colistin sulphate (92.86%) (Fig. 1), which may be attributed to improper use of bactericidal agents in our country's intensive care units and insufficient infection control measures. The medical staff has inevitably reintroduced older antimicrobials such as colistin, which is the last resort for treating MDR and XDR infections leading to the spread of colistin-resistant P. aeruginosa [54]. Additionally, similar to other antibiotics, the use of colistin is not just limited to humans, as it has been frequently applied to animals to promote growth and to agriculture to ensure high production, therefore the development of colistin-resistant Gram-negative bacteria has been considerably impacted by this practice [5, 55]. The current study also revealed a high rate of resistance towards Polymyxin B (95.7%) (Fig. 1), whilst the pattern of resistance usually increase by time, as a lower level of resistance was found in an older study in Egypt, where 46% and 28.7% of P. aeruginosa isolates were resistant to polymyxin B and colistin sulfate, respectively [56]. Abd El-Baky et al., 2020 also reported that 21.3% of P. aeruginosa isolates showed resistance to colistin antibiotic [5]. This varriable sensitivity to colistin in various studies from Egypt might be attributed to differences in the geographic zones or the use of different antibiotic regimens in these areas [57]. Previously, Farhan et al., 2019 has observed that 74.1% of ESBL-producing P. aeruginosa were polymyxin B resistant, while 37% were colistin resistant [56]. The current study showed that 97.5% of ESBL-producing XDR-PA exhibited polymyxin B resistance, while 95% were colistin resistant. Plasmid-mediated colistin resistance is associated with the addition of a phosphoethanolamine (PEtN) moiety to the anionic phosphate groups of lipid A; the binding site for polymyxins (colistin and polymyxin B). As a consequence, lipid A has lower anionic charges, which prevents electrostatic interactions with cationic polypeptide molecules such as polymyxins, resulting in antimicrobial resistance. The transferable plasmid-mediated colistin resistance gene, mcr, is a phosphoethanolamine transferase enzyme, which transfers phosphoethanolamine to lipid A through the horizontal transfer of colistin resistance [58]. In our study, genetic detection of the colistin resistance gene showed that 9 isolates were positive for mcr-1 (12.3% of colistin resistant isolates; 12.9% of total isolates) (Table 4, Fig. 1C Supp.). Similar results were also reported in a previous study, where the mcr-1 gene was amplified in 10% of colistin-resistant P. aeruginosa isolates; 1.19% of total isolates [55]. Colistin-resistant isolates lacking mcr-1 gene might have been subjected to mutations due to the long-term use of antibiotics [5]. Further studies are also needed to investigate the exact mechanism of polymyxins resistance and the prevalence of other mcr genes among P. aeruginosa isolates.
Plasmids, transposons, insertion sequences and integrons are examples of movable genetic elements that play an important role in the horizontal transfer of resistance genes, thus increasing antibiotic resistance. The most frequent cause of multiple antibiotic resistance (MAR) is the existence of plasmids, which have the ability to carry one or more resistance genes, each of which encodes a specific antibiotic resistance trait [41]. Moreover, according to previous studies, more than 130 unique gene cassettes have been identified in Class 1 integrons, the majority of which encode proteins with resistance to all major antibiotic classes [59, 60]. Among the screened genes (intI, traA, tnp513, and merA), intI was the most detected gene as it was amplified in 67 (95.7%) isolates, followed by tnp513 gene, which was harbored by 47 (67.1%) isolates, and merA gene, which was present in 43 (61.4%) isolates (Fig. 1D Supp.). Concerning XDR-PA isolates, intI was also the most frequently detected gene, as it was amplified in 52 isolates (98.1% of XDR-PA), followed by tnp513 and merA, which were present in 64.2% and 60.4% of XDR-PA isolates, respectively. On the other hand, traA was amplified in 24.5% of XDR-PA isolates as shown in Fig. 5. Our observations are in agreement with another published study, where Li et al., 2016 previously reported that intI, tnp513 and merA were the most detected genes among XDR P. aeruginosa isolates [1]. The current study revealed that 98% of the XDR isolates harbored at least one gene associated with mobile genetic elements, 47% of the XDR-PA clinical isolates co-harbored three or four mobile genetic element genes, in agreement with a previous report [1], which might have aided the evolution of these extensively drug-resistant P. aeruginosa strains.
ERIC-PCR is a simple and fast typing method that has been widely used in routine epidemiological studies in P. aeruginosa. Based on the dendrogram map, six major clusters, representing 66 isolates, were detected as shown in Fig. 5. It was found that both A and B clusters grouped only isolates collected from H1 hospital, while cluster C contained only isolates from H2 hospital. In contrast, cluster E grouped all isolates from H3 hospital (with similarity > 95%), in addition to one isolate from H2 hospital, collected at the same period of time. However, clusters D and F contained isolates from both H1 and H2 hospitals, indicating microbial dissemination of the same isolates intra-and inter-hospital, as previously reported in other studies [36, 61]. Interestingly, we found that most of the MDR isolates (11/13) grouped into cluster F. Furthermore, clusters A and B were unique for XDR-PA isolates. As previously reported [62, 63], our results suggest that ERIC-PCR typing may be essential in identifying the source of P. aeruginosa transmission in hospitals and for regular epidemiological surveillance. Therefore, ERIC-PCR can be used as an ideal screening genotyping technique for P. aeruginosa.
Conclusions
In conclusion, the current study revealed that the clinical XDR-PA isolates were resistant to a variety of antimicrobial agents due to several mechanisms and co-harboring multiple antibiotic resistance genes. Additionally, 98% of the XDR-PA isolates possessed at least one gene associated with mobile genetic elements, which could have facilitated the fast evolution of these XDR-PA strains. The increased rates of antimicrobial resistance and the appearance of XDR-PA hospital-acquired infections are becoming a serious public health threat globally. High rates of multidrug resistance draw attention to the urgent need for widespread, local antimicrobial resistance surveillance and efficient multidrug resistance overcoming strategies. The monitoring of both multiple antibiotic resistance (MAR) and antibiotic consumption particularly in hospital-acquired infections is critical for setting up and audit of such strategies.
Supplementary Information
Supplementary Material 2. Fig. 1 Supp. Agarose gel electrophoresis for detection of rsistance-encoding genes and movablegenetic elements among P. aeruginosaclinical isolates using PCR. Lane M is the molecular weight DNA marker. Lane C is a negative control. A Carbapenemases-encoding genes. B Aminoglycosides-resistance genes. C Colistin-resistance gene. D Genes associated with mavable genetic elements.
Acknowledgements
Many thanks to Prof. Mona I. Shaaban, department of Microbiology and Immunology at Faculty of Pharmacy, Mansoura University, Egypt for providing the standard strains used in this study.
Abbreviations
- XDR
Extensively drug-resistant
- MDR
Multi-drug resistant
- PDR
Pandrug-resistant
- MIC
Minimum inhibitory concentration
- ICU
Intensive care units
- XDR-PA
Extensively drug-resistant Pseudomonas aeruginosa
- AMEs
Aminoglycoside-modifying enzymes
- LB
Luria–Bertani
- MARI
Multiple antibiotic resistance index
- UPGMA
Unweighted pair group method with arithmetic mean clustering method
- MHT
Modified Hodge test
- MBL
Metallo β-lactamase
- ESBL
Extended-spectrum β-lactamase
- ERIC-PCR
Enterobacterial repetitive intergenic consensus polymerase chain reaction
- CDT
Combined disk test
Authors’ contributions
RB, MMAE and AMA designed and conceived the study. MAA isolated the specimens and performed the phenotypic and genotypic analysis. MAA tabulated the results and wrote the manuscript. AMA, MMAE, and RB revised the manuscript. All authors reviewed and approved the final manuscript.
Funding
Open access funding provided by The Science, Technology & Innovation Funding Authority (STDF) in cooperation with The Egyptian Knowledge Bank (EKB). No funding was obtained for this study.
Availability of data and materials
All data generated or analyzed in the present work are included in this article. The datasets analyzed and used during the present work are available from the corresponding author on reasonable request.
Declarations
Ethics approval and consent to participate
This work was the approval from the Research Ethics Committee of faculty of Pharmacy, Mansoura University, Egypt, which is in accordance with the Code of Ethics of the World Medical Association (Declaration of Helsinki regarding the involvement of human subjects), our protocol was approved by the committee with the ethical codes 2019–110 and 2023–16, the need for consent to participate was waived by the institutional review board.
Consent for publication
Not applicable.
Competing interests
The authors declare no competing interests.
Footnotes
Publisher’s Note
Springer Nature remains neutral with regard to jurisdictional claims in published maps and institutional affiliations.
References
- 1.Li J, Zou M, Dou Q, Hu Y, Wang H, Yan Q, et al. Characterization of clinical extensively drug-resistant Pseudomonas aeruginosa in the Hunan province of China. Ann Clin Microbiol Antimicrob. 2016;15(1):1–7. doi: 10.1186/s12941-016-0148-y. [DOI] [PMC free article] [PubMed] [Google Scholar]
- 2.Mahmoud AB, Zahran WA, Hindawi GR, Labib AZ, Galal RJJ. Prevalence of multidrug-resistant Pseudomonas aeruginosa in patients with nosocomial infections at a university hospital in Egypt, with special reference to typing methods. Virol Microbiol. 2013;13:165–259. [Google Scholar]
- 3.Peleg AY, Hooper DC. Hospital-acquired infections due to gram-negative bacteria. N Engl J Med. 2010;362(19):1804–1813. doi: 10.1056/NEJMra0904124. [DOI] [PMC free article] [PubMed] [Google Scholar]
- 4.Rosenthal VD, Duszynska W, Ider B-E, Gurskis V, Al-Ruzzieh MA, Myatra SN, et al. International Nosocomial Infection Control Consortium (INICC) report, data summary of 45 countries for 2013–2018, adult and pediatric units, device-associated module. Am J Infect Control. 2021;49(10):1267–1274. doi: 10.1016/j.ajic.2021.04.077. [DOI] [PubMed] [Google Scholar]
- 5.Abd El-Baky RM, Masoud SM, Mohamed DS, Waly NG, Shafik EA, Mohareb DA, et al. Prevalence and some possible mechanisms of colistin resistance among multidrug-resistant and extensively drug-resistant Pseudomonas aeruginosa. Infect Drug Resist. 2020;13:323. doi: 10.2147/IDR.S238811. [DOI] [PMC free article] [PubMed] [Google Scholar]
- 6.Salam MA, Al-Amin MY, Salam MT, Pawar JS, Akhter N, Rabaan AA, et al. Antimicrobial resistance: a growing serious threat for global public health. Healthcare (Basel) 2023;11(13):1946. doi: 10.3390/healthcare11131946. [DOI] [PMC free article] [PubMed] [Google Scholar]
- 7.Magiorakos AP, Srinivasan A, Carey RB, Carmeli Y, Falagas ME, Giske CG, et al. Multidrug-resistant, extensively drug-resistant and pandrug-resistant bacteria: an international expert proposal for interim standard definitions for acquired resistance. Clin Microbiol Infect. 2012;18(3):268–281. doi: 10.1111/j.1469-0691.2011.03570.x. [DOI] [PubMed] [Google Scholar]
- 8.El-Baz R, Said HS, Abdelmegeed ES, Barwa RJ. Characterization of virulence determinants and phylogenetic background of multiple and extensively drug resistant Escherichia coli isolated from different clinical sources in Egypt. Appl Microbiol Biotechnol. 2022;106(3):1279–1298. doi: 10.1007/s00253-021-11740-x. [DOI] [PMC free article] [PubMed] [Google Scholar]
- 9.Bakht M, Alizadeh SA, Rahimi S, Kazemzadeh Anari R, Rostamani M, Javadi A, et al. Phenotype and genetic determination of resistance to common disinfectants among biofilm-producing and non-producing Pseudomonas aeruginosa strains from clinical specimens in Iran. BMC Microbiol. 2022;22(1):124. doi: 10.1186/s12866-022-02664-1. [DOI] [PMC free article] [PubMed] [Google Scholar]
- 10.Beige F, Salehi MB, Bahador N, Mobasherzadeh SJ. Plasmid mediated antibiotic resistance in isolated bacteria from burned patients. Jundishapur J Microbiol. 2015;8(1):e13567. doi: 10.5812/jjm.13567. [DOI] [PMC free article] [PubMed] [Google Scholar]
- 11.Palavutitotai N, Jitmuang A, Tongsai S, Kiratisin P, Angkasekwinai NJ. Epidemiology and risk factors of extensively drug-resistant Pseudomonas aeruginosa infections. PLoS ONE. 2018;13(2):e0193431. doi: 10.1371/journal.pone.0193431. [DOI] [PMC free article] [PubMed] [Google Scholar]
- 12.El-Mahdy R, El-Kannishy GJ. Virulence factors of carbapenem-resistant Pseudomonas aeruginosa in hospital-acquired infections in Mansoura, Egypt. Infect Drug Resist. 2019;12:3455–3461. doi: 10.2147/IDR.S222329. [DOI] [PMC free article] [PubMed] [Google Scholar]
- 13.Feizabadi MM, Majnooni A, Nomanpour B, Fatolahzadeh B, Raji N, Delfani S, et al. Direct detection of Pseudomonas aeruginosa from patients with healthcare associated pneumonia by real time PCR. Infect Genet Evol. 2010;10(8):1247–1251. doi: 10.1016/j.meegid.2010.08.008. [DOI] [PubMed] [Google Scholar]
- 14.Barwa R, Shaaban M. Molecular characterization of Klebsiella pneumoniae clinical isolates with elevated resistance to carbapenems. Open Microbiol J. 2017;11:152. doi: 10.2174/1874285801711010152. [DOI] [PMC free article] [PubMed] [Google Scholar]
- 15.Shaaban M, Al-Qahtani A, Al-Ahdal M, Barwa R. Molecular characterization of resistance mechanisms in Pseudomonas aeruginosa isolates resistant to carbapenems. J Infect Dev Ctries. 2017;11(12):935–943. doi: 10.3855/jidc.9501. [DOI] [PubMed] [Google Scholar]
- 16.Warburg G, Hidalgo-Grass C, Partridge SR, Tolmasky ME, Temper V, Moses AE, et al. A carbapenem-resistant Klebsiella pneumoniae epidemic clone in Jerusalem: sequence type 512 carrying a plasmid encoding aac (6′)-Ib. J Antimicrob Chemother. 2012;67(4):898–901. doi: 10.1093/jac/dkr552. [DOI] [PubMed] [Google Scholar]
- 17.Hamed SM, Aboshanab KM, Elkhatib WF, Ashour MSJ. Aminoglycoside resistance patterns of certain gram negative uropathogens recovered from hospitalized Egyptian patients. Br Microbiol Res J. 2013;3:678–691. [Google Scholar]
- 18.El-Far A, Samir S, El-Gebaly E, Omar M, Dahroug H, El-Shenawy A, et al. High rates of aminoglycoside methyltransferases associated with metallo-beta-lactamases in multidrug-resistant and extensively drug-resistant Pseudomonas aeruginosa clinical isolates from a tertiary care hospital in Egypt. Infect Drug Resist. 2021;14:4849. doi: 10.2147/IDR.S335582. [DOI] [PMC free article] [PubMed] [Google Scholar]
- 19.Rebelo AR, Bortolaia V, Kjeldgaard JS, Pedersen SK, Leekitcharoenphon P, Hansen IM, et al. Multiplex PCR for detection of plasmid-mediated colistin resistance determinants, mcr-1, mcr-2, mcr-3, mcr-4 and mcr-5 for surveillance purposes. Eurosurveillance. 2018;23(6):17–00672. doi: 10.2807/1560-7917.ES.2018.23.6.17-00672. [DOI] [PMC free article] [PubMed] [Google Scholar]
- 20.Jin H, Xu X-m, Mi Z-h, Mou Y, Liu PJ. Drug-resistant gene based genotyping for Acinetobacter baumannii in tracing epidemiological events and for clinical treatment within nosocomial settings. Chin Med J. 2009;122(03):301–306. [PubMed] [Google Scholar]
- 21.Xia Y, Liang Z, Su X, Xiong YJ. Characterization of carbapenemase genes in Enterobacteriaceae species exhibiting decreased susceptibility to carbapenems in a university hospital in Chongqing, China. Ann Lab Med. 2012;32(4):270–275. doi: 10.3343/alm.2012.32.4.270. [DOI] [PMC free article] [PubMed] [Google Scholar]
- 22.Hudzicki JJ. Kirby-Bauer disk diffusion susceptibility test protocol. Am Soc Microbiol. 2009;15:55–63. [Google Scholar]
- 23.CLSI . Clinical Laboratory Standards Institute: Performance standards for antimicrobial susceptibility testing, M100. Wayne: CLSI; 2020. [Google Scholar]
- 24.EUCAST. European Committee on Antimicrobial Susceptibility Testing. EUCAST clinical breakpoint table. 2021. https://www.eucast.org/clinical_breakpoints/.
- 25.Krumperman PHJ. Multiple antibiotic resistance indexing of Escherichia coli to identify high-risk sources of fecal contamination of foods. Appl Environ Microbiol. 1983;46(1):165–170. doi: 10.1128/aem.46.1.165-170.1983. [DOI] [PMC free article] [PubMed] [Google Scholar]
- 26.Garcia-Vallvé S, Palau J, Romeu AJ. Horizontal gene transfer in glycosyl hydrolases inferred from codon usage in Escherichia coli and Bacillus subtilis. Mol Biol Evol. 1999;16(9):1125–1134. doi: 10.1093/oxfordjournals.molbev.a026203. [DOI] [PubMed] [Google Scholar]
- 27.Ahmed N, Ali Z, Riaz M, Zeshan B, Wattoo JI, Aslam MNJ. Evaluation of antibiotic resistance and virulence genes among clinical isolates of Pseudomonas aeruginosa from cancer patients. Asian Pac J Cancer Prev. 2020;21(5):1333. doi: 10.31557/APJCP.2020.21.5.1333. [DOI] [PMC free article] [PubMed] [Google Scholar]
- 28.Behzadi P, Gajdács M, Pallós PT, Ónodi Br, Stájer A, Matusovits D, et al. Relationship between biofilm-formation, phenotypic virulence factors and antibiotic resistance in environmental Pseudomonas aeruginosa. Pathogens. 2022;11(9):1015. doi: 10.3390/pathogens11091015. [DOI] [PMC free article] [PubMed] [Google Scholar]
- 29.Ohadian Moghadam S, Afshar D, Nowroozi MR, Behnamfar A, Farzin A. Molecular epidemiology of carbapenemase-producing Pseudomonas aeruginosa isolated from an Iranian university hospital: evidence for spread of high-risk clones. Infect Drug Resist. 2020;13:1583–1592. doi: 10.2147/IDR.S253756. [DOI] [PMC free article] [PubMed] [Google Scholar]
- 30.Khalifa SM, Abd El-Aziz AM, Hassan R, Abdelmegeed ESJ. β-lactam resistance associated with β-lactamase production and porin alteration in clinical isolates of E. coli and K. pneumoniae. PLoS ONE. 2021;16(5):e0251594. doi: 10.1371/journal.pone.0251594. [DOI] [PMC free article] [PubMed] [Google Scholar]
- 31.Kaur A, Singh S. Prevalence of extended spectrum betalactamase (ESBL) and metallobetalactamase (MBL) producing Pseudomonas aeruginosa and Acinetobacter baumannii isolated from various clinical samples. J Pathog. 2018;2018:6845985. doi: 10.1155/2018/6845985. [DOI] [PMC free article] [PubMed] [Google Scholar]
- 32.Salimi F, Eftekhar F. Prevalence of blAbstractP and blaVIM gene carriage in metallo-\beta-lactamase-producing burn isolates of Pseudomonas aeruginosa in Tehran. Turk J Med Sci. 2014;44(3):511–514. doi: 10.3906/sag-1302-67. [DOI] [PubMed] [Google Scholar]
- 33.Joji RM, Al-Rashed N, Saeed NK, Bindayna KM. Detection of VIM and NDM-1 metallo-beta-lactamase genes in carbapenem-resistant Pseudomonas aeruginosa clinical strains in Bahrain. J Lab Physicians. 2019;11(02):138–143. doi: 10.4103/JLP.JLP_118_18. [DOI] [PMC free article] [PubMed] [Google Scholar]
- 34.Heras J, Domínguez C, Mata E, Pascual V, Lozano C, Torres C, et al. GelJ–a tool for analyzing DNA fingerprint gel images. BMC Bioinformatics. 2015;16(1):1–8. doi: 10.1186/s12859-015-0703-0. [DOI] [PMC free article] [PubMed] [Google Scholar]
- 35.Saitou N, Nei MJ. The neighbor-joining method: a new method for reconstructing phylogenetic trees. Mol Biol Evol. 1987;4(4):406–425. doi: 10.1093/oxfordjournals.molbev.a040454. [DOI] [PubMed] [Google Scholar]
- 36.Eladawy M, El-Mowafy M, El-Sokkary MM, Barwa RJ. Antimicrobial resistance and virulence characteristics in ERIC-PCR typed biofilm forming isolates of P. aeruginosa. Microb Pathog. 2021;158:105042. doi: 10.1016/j.micpath.2021.105042. [DOI] [PubMed] [Google Scholar]
- 37.Teixeira B, Rodulfo H, Carreno N, Guzman M, Salazar E, Donato MDJ. Aminoglycoside resistance genes in Pseudomonas aeruginosa isolates from Cumana, Venezuela. Rev Inst Med Trop Sao Paulo. 2016;58:13. doi: 10.1590/S1678-9946201658013. [DOI] [PMC free article] [PubMed] [Google Scholar]
- 38.De Bentzmann S, Plésiat PJ. The Pseudomonas aeruginosa opportunistic pathogen and human infections. Environ Microbiol. 2011;13(7):1655–1665. doi: 10.1111/j.1462-2920.2011.02469.x. [DOI] [PubMed] [Google Scholar]
- 39.Edward EA, El Shehawy MR, Abouelfetouh A, Aboulmagd EJ. Prevalence of different virulence factors and their association with antimicrobial resistance among Pseudomonas aeruginosa clinical isolates from Egypt. BMC Microbiol. 2023;23(1):1–13. doi: 10.1186/s12866-023-02897-8. [DOI] [PMC free article] [PubMed] [Google Scholar]
- 40.Riaz S, Faisal M, Hasnain SJ. Antibiotic susceptibility pattern and multiple antibiotic resistances (MAR) calculation of extended spectrum β-lactamase (ESBL) producing Escherichia coli and Klebsiella species in Pakistan. Afr J Biotech. 2011;10(33):6325–6331. [Google Scholar]
- 41.Osundiya O, Oladele R, Oduyebo OO. Multiple antibiotic resistance (MAR) indices of Pseudomonas and Klebsiella species isolates in Lagos University Teaching Hospital. Afr J Clin Exp Microbiol. 2013;14(3):164–168. [Google Scholar]
- 42.Rahal JJ. The role of carbapenems in initial therapy for serious Gram-negative infections. Crit Care. 2008;12(4):1–7. doi: 10.1186/cc6821. [DOI] [PMC free article] [PubMed] [Google Scholar]
- 43.Basha AM, El-Sherbiny GM, Mabrouk MIJ. Phenotypic characterization of the Egyptian isolates “extensively drug-resistant Pseudomonas aeruginosa” and detection of their metallo-β-lactamases encoding genes. Bull Natl Res Cent. 2020;44(1):1–11. [Google Scholar]
- 44.Shiralizadeh S, Keramat F, Hashemi SH, Majzoobi MM, Azimzadeh M, Alikhani MS, et al. Investigation of antimicrobial resistance patterns and molecular typing of Pseudomonas aeruginosa isolates among Coronavirus disease-19 patients. BMC Microbiol. 2023;23(1):84. doi: 10.1186/s12866-023-02825-w. [DOI] [PMC free article] [PubMed] [Google Scholar]
- 45.Basha AM, El-Sherbiny GM, Mabrouk MIJ. Phenotypic characterization of the Egyptian isolates “extensively drug-resistant Pseudomonas aeruginosa" and detection of their metallo-β-lactamases encoding genes. Bulletin of the National Research Centre. 2020;44(1):1–11. [Google Scholar]
- 46.Azimi A, Peymani A, Pour PKJ. Phenotypic and molecular detection of metallo-β-lactamase-producing Pseudomonas aeruginosa isolates from patients with burns in Tehran, Iran. Rev Soc Bras Med Trop. 2018;51:610–615. doi: 10.1590/0037-8682-0174-2017. [DOI] [PubMed] [Google Scholar]
- 47.Gill J, Arora S, Khanna S, Kumar KHJ. Prevalence of multidrug-resistant, extensively drug-resistant, and pandrug-resistant Pseudomonas aeruginosa from a tertiary level intensive care unit. J Glob Infect Dis. 2016;8(4):155. doi: 10.4103/0974-777X.192962. [DOI] [PMC free article] [PubMed] [Google Scholar]
- 48.Ahmadian L, Norouzi Bazgir Z, Ahanjan M, Valadan R, Goli HR. Role of Aminoglycoside-Modifying Enzymes (AMEs) in Resistance to Aminoglycosides among Clinical Isolates of Pseudomonas aeruginosa in the North of Iran. BioMed Res Int. 2021;2021:7077344. doi: 10.1155/2021/7077344. [DOI] [PMC free article] [PubMed] [Google Scholar]
- 49.Asghar A, Ahmed OJ. Prevalence of aminoglycoside resistance genes in Pseudomonas aeruginosa isolated from a tertiary care hospital in Makkah. KSA Clin Pract. 2018;15(2):541–547. [Google Scholar]
- 50.Mendes RE, Castanheira M, Toleman MA, Sader HS, Jones RN, Walsh TRJ. Characterization of an integron carrying bla IMP-1 and a new aminoglycoside resistance gene, aac (6)-31, and its dissemination among genetically unrelated clinical isolates in a Brazilian hospital. Antimicrob Agents Chemother. 2007;51(7):2611–2614. doi: 10.1128/AAC.00838-06. [DOI] [PMC free article] [PubMed] [Google Scholar]
- 51.Sánchez-Martinez G, Garza-Ramos UJ, Reyna-Flores FL, Gaytán-Martínez J, Lorenzo-Bautista IG, Silva-Sanchez JJ. In169, a new class 1 integron that encoded blaimp-18 in a multidrug-resistant Pseudomonas aeruginosa isolate from Mexico. Arch Med Res. 2010;41(4):235–239. doi: 10.1016/j.arcmed.2010.05.006. [DOI] [PubMed] [Google Scholar]
- 52.Jahangiri A, Neshani A, Mirhosseini SA, Ghazvini K, Zare H, Sedighian HJ. Synergistic effect of two antimicrobial peptides, Nisin and P10 with conventional antibiotics against extensively drug-resistant Acinetobacter baumannii and colistin-resistant Pseudomonas aeruginosa isolates. Microb Pathog. 2021;150:104700. doi: 10.1016/j.micpath.2020.104700. [DOI] [PubMed] [Google Scholar]
- 53.Osei Sekyere JJ. Mcr colistin resistance gene: a systematic review of current diagnostics and detection methods. Microbiologyopen. 2019;8(4):e00682. doi: 10.1002/mbo3.682. [DOI] [PMC free article] [PubMed] [Google Scholar]
- 54.Feng L, Xu M, Zeng W, Zhang X, Wang S, Yao Z, et al. Evaluation of the antibacterial, antibiofilm, and anti-virulence effects of acetic acid and the related mechanisms on colistin-resistant Pseudomonas aeruginosa. BMC Microbiol. 2022;22(1):1–13. doi: 10.1186/s12866-022-02716-6. [DOI] [PMC free article] [PubMed] [Google Scholar]
- 55.Hameed F, Khan MA, Muhammad H, Sarwar T, Bilal H, Rehman TU. Plasmid-mediated mcr-1 gene in Acinetobacter baumannii and Pseudomonas aeruginosa: first report from Pakistan. Rev Soc Bras Med Trop. 2019;52:e20190237. doi: 10.1590/0037-8682-0237-2019. [DOI] [PubMed] [Google Scholar]
- 56.Farhan SM, Ibrahim RA, Mahran KM, Hetta HF, Abd El-Baky RMJI. Antimicrobial resistance pattern and molecular genetic distribution of metallo-β-lactamases producing Pseudomonas aeruginosa isolated from hospitals in Minia Egypt. Infect Drug Resist. 2019;12:2125–2133. doi: 10.2147/IDR.S198373. [DOI] [PMC free article] [PubMed] [Google Scholar]
- 57.Abozahra R, Gaballah A, Abdelhamid SMJ. Prevalence of the colistin resistance gene MCR-1 in colistin-resistant Klebsiella pneumoniae in Egypt. AIMS Microbiol. 2023;9(2):177. doi: 10.3934/microbiol.2023011. [DOI] [PMC free article] [PubMed] [Google Scholar]
- 58.Poirel L, Jayol A, Nordmann PJ. Polymyxins: antibacterial activity, susceptibility testing, and resistance mechanisms encoded by plasmids or chromosomes. Clin Microbiol Rev. 2017;30(2):557–596. doi: 10.1128/CMR.00064-16. [DOI] [PMC free article] [PubMed] [Google Scholar]
- 59.Partridge SR, Tsafnat G, Coiera E, Iredell JRJ. Gene cassettes and cassette arrays in mobile resistance integrons. FEMS Microbiol Rev. 2009;33(4):757–784. doi: 10.1111/j.1574-6976.2009.00175.x. [DOI] [PubMed] [Google Scholar]
- 60.Liu M, Ma J, Jia W, Li WJ. Antimicrobial resistance and molecular characterization of gene cassettes from class 1 integrons in Pseudomonas aeruginosa strains. Microb Drug Resist. 2020;26(6):670–676. doi: 10.1089/mdr.2019.0406. [DOI] [PMC free article] [PubMed] [Google Scholar]
- 61.Zou M, Wang H, Shui J, Li J, Hu Y, Dou Q, et al. Characterization of clinical extensively drug resistant Pseudomonas aeruginosa from a Chinese teaching hospital. J Infect Dev Ctries. 2018;12(10):835–841. doi: 10.3855/jidc.10743. [DOI] [PubMed] [Google Scholar]
- 62.Khosravi AD, Hoveizavi H, Mohammadian A, Farahani A, Jenabi AJ. Genotyping of multidrug-resistant strains of Pseudomonas aeruginosa isolated from burn and wound infections by ERIC-PCR. Acta Cir Bras. 2016;31:206–211. doi: 10.1590/S0102-865020160030000009. [DOI] [PubMed] [Google Scholar]
- 63.Dawson SL, Fry JC, Dancer BNJ. A comparative evaluation of five typing techniques for determining the diversity of fluorescent pseudomonads. J Microbiol Methods. 2002;50(1):9–22. doi: 10.1016/s0167-7012(02)00003-9. [DOI] [PubMed] [Google Scholar]
Associated Data
This section collects any data citations, data availability statements, or supplementary materials included in this article.
Supplementary Materials
Supplementary Material 2. Fig. 1 Supp. Agarose gel electrophoresis for detection of rsistance-encoding genes and movablegenetic elements among P. aeruginosaclinical isolates using PCR. Lane M is the molecular weight DNA marker. Lane C is a negative control. A Carbapenemases-encoding genes. B Aminoglycosides-resistance genes. C Colistin-resistance gene. D Genes associated with mavable genetic elements.
Data Availability Statement
All data generated or analyzed in the present work are included in this article. The datasets analyzed and used during the present work are available from the corresponding author on reasonable request.





